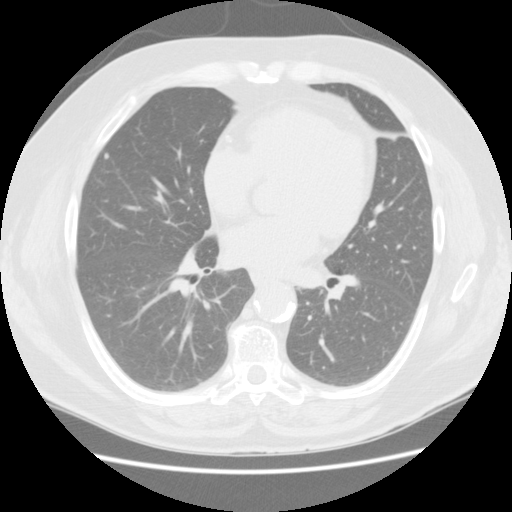

胸部CT画像の読影を支援するEIRL Chest CTの販売を開始
2022年4月4日(月)、エルピクセル株式会社(本社:東京都千代田区、代表取締役:鎌田富久、島原佑基、以下「エルピクセル 」)は、胸部 CT 画像の肺野領域において、観察対象の領域(関心領域)を抽出し、その体積と最大径を測定するEIRL Chest CTについて、「医薬品、医療機器等の品質、有効性及び安全性の確保等に関する法律(医薬品医療機器等法)」に基づき、指定管理医療機器の製造販売認証(認証番号:304AGBZX00037000)を取得し、販売を開始いたしました。
本製品は、胸部CT画像から肺野領域の組織について、使用者が設定した基準値に基づくCT値から「関心領域」を抽出し、その体積と最大径を自動計測します。計測した最大径が閾値以上となった場合には、画像上に色付けして表示します。この抽出・計測・表示機能は、医師が胸部CT画像を対象に読影診断を行う際に併用することで、肺野周辺組織とCT値が異なる肺結節等の視認性向上に寄与することが期待されます
本製品は、胸部CT画像から肺野領域の組織について、使用者が設定した基準値に基づくCT値から「関心領域」を抽出し、その体積と最大径を自動計測します。計測した最大径が閾値以上となった場合には、画像上に色付けして表示します。この抽出・計測・表示機能は、医師が胸部CT画像を対象に読影診断を行う際に併用することで、肺野周辺組織とCT値が異なる肺結節等の視認性向上に寄与することが期待されます

【 EIRL Chest CT の開発背景】
肺がんは、日本における死因第一位である悪性新生物(腫瘍)で、高い死亡数・死亡率を示しています(1)。こうした状況を改善するためには、何よりも早期発見と早期治療が肝要であり、肺がんが疑われる肺結節を早期に発見する目的で、胸部X線検査やCT検査が実施されています。一般に、自治体や事業所等の定期健康診断で行われる胸部X線検査において、何らかの所見が認められた場合には、精密検査として胸部CT検査を行います。また、入院患者のフォローアップとして定期的に胸部CT検査が行われるなど、医療施設では定常的に胸部CT検査が行われています。日本CT検診学会が示す「読影の留意点」の一つとして、肺がん(肺結節)について「10 mm を超えても見落とす事あり(2)」と指摘されるなど、胸部CT検査には高い精度の維持が求められています。しかしながら、医師の業務逼迫等により1症例にかけられる読影時間には限度があります。さらに、見落としや誤診を防ぐための「二重読影」を実施していない医療施設は3割以上に及ぶとされています(3)。
そこで、エルピクセルでは、胸部 CT 画像の肺野領域において肺結節候補域を観察対象の領域(関心領域)として抽出し、その体積と最大径を測定することで、医師の読影診断を支援するソフトウェアの開発に取り組みました。
(1)厚生労働省「令和2年(2020)人口動態統計月報年計」(https://www.mhlw.go.jp/toukei/saikin/hw/jinkou/geppo/nengai20/dl/h7.pdf)
(2)日本CT検診学会「低線量CT による肺がん検診の肺結節の 判定基準と経過観察の考え方 第5版」(https://www.jscts.org/pdf/guideline/gls5th201710.pdf)
(3)人間ドック学会「本学会会員施設における低線量CT肺がん検診の実施状況に関する調査報告」(https://www.jstage.jst.go.jp/article/ningendock/33/5/33_739/_pdf/-char/ja)
- 肺結節について
- X線画像では、空気は黒く、骨・筋肉・血液などの水分は白く写ります。通常は黒く映る部分が白く見えた場合、それを「結節影」と呼び、肺がん、肺結核、肺炎などの可能性が疑われます。定期健康診断などで実施される胸部X線・CT検査において、そういった「結節影」が見られた場合には、精密検査によって確認をする必要があります。
【EIRL Chest CTによる表示例】
① 標準線量CT

② 低線量CT


- 低線量CTについて
- 通常のCTに比べ、被検査者に与える被ばく量を軽減することが可能です。一方、撮影される画像は、通常のCTに比べて質が低下する傾向にあり、読影診断の難易度が高まると言われています。
エルピクセル株式会社 営業本部
TEL:03-6259-1713 Mail:eirl-cs@lpixel.net
URL:https://marketing.eirl.ai/ja/contact/
【AI画像診断支援技術について】
高度化するモダリティとともに、医療画像診断の作業は膨大化しています。AIを活用した独自のアルゴリズムによって、脳MRI、胸部X線などの医療画像情報を解析し、効率的で、正確な診断が出来る環境の提供を目指します。
EIRLプロダクトサイト(医療従事者向け):https://eirl.ai/ja/
【エルピクセル株式会社について】
エルピクセル株式会社は、ライフサイエンス領域の画像解析に強みを持ち、医療・製薬・農業分野において画像解析技術、とりわけ人工知能技術を応用することで、高精度のソフトウエアを開発してまいりました。医師の診断を支援するAI画像診断支援技術「EIRL(エイル)」、創薬に特化した画像解析AI「IMACEL(イマセル)」を軸に事業を展開しています。
このプレスリリースには、メディア関係者向けの情報があります
メディアユーザーログイン既に登録済みの方はこちら
メディアユーザー登録を行うと、企業担当者の連絡先や、イベント・記者会見の情報など様々な特記情報を閲覧できます。※内容はプレスリリースにより異なります。
すべての画像
